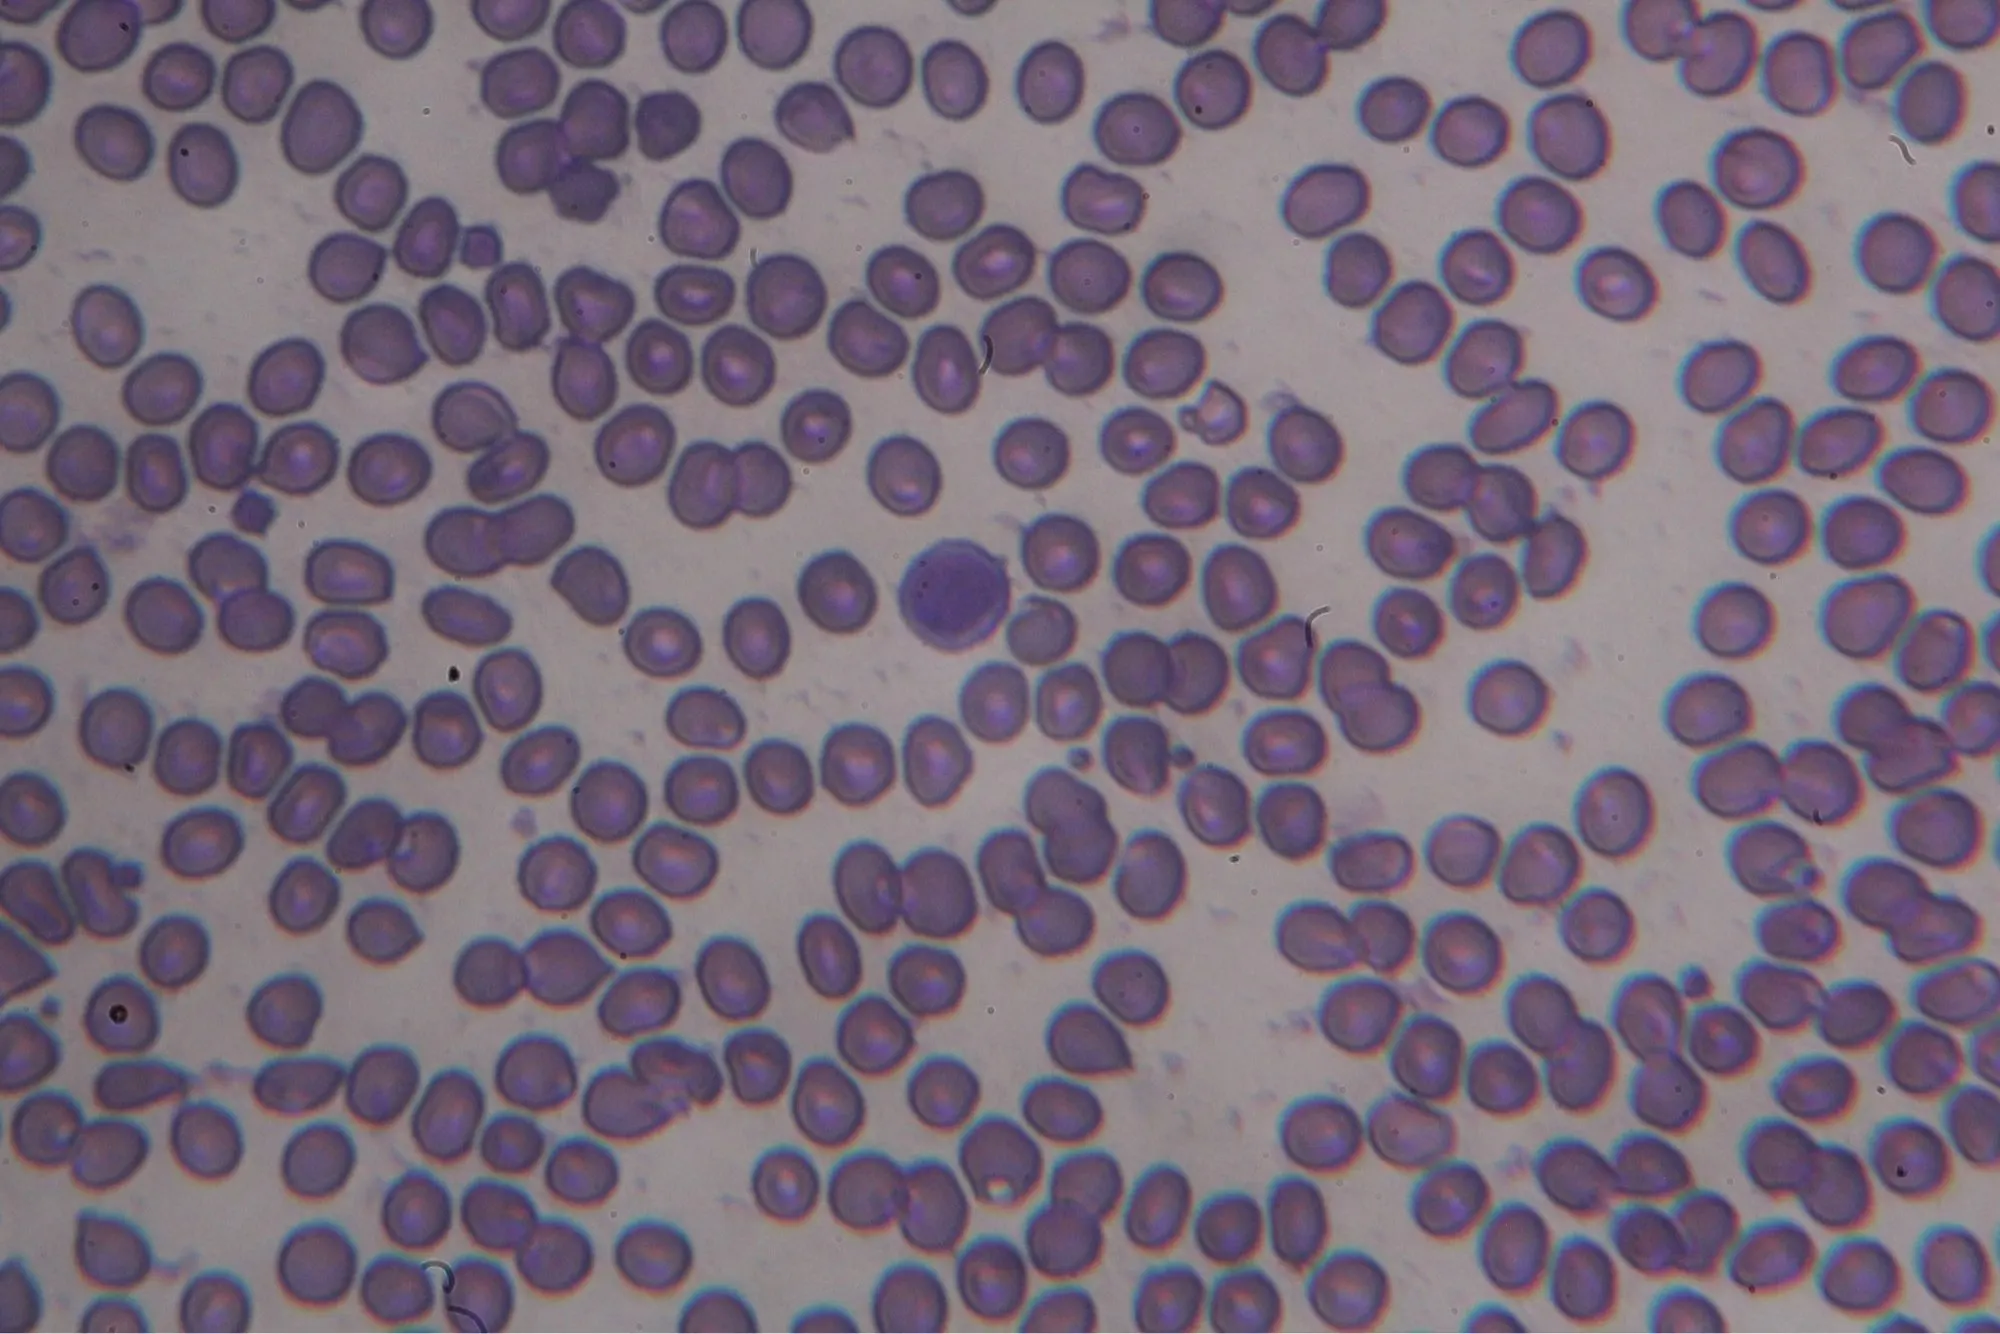
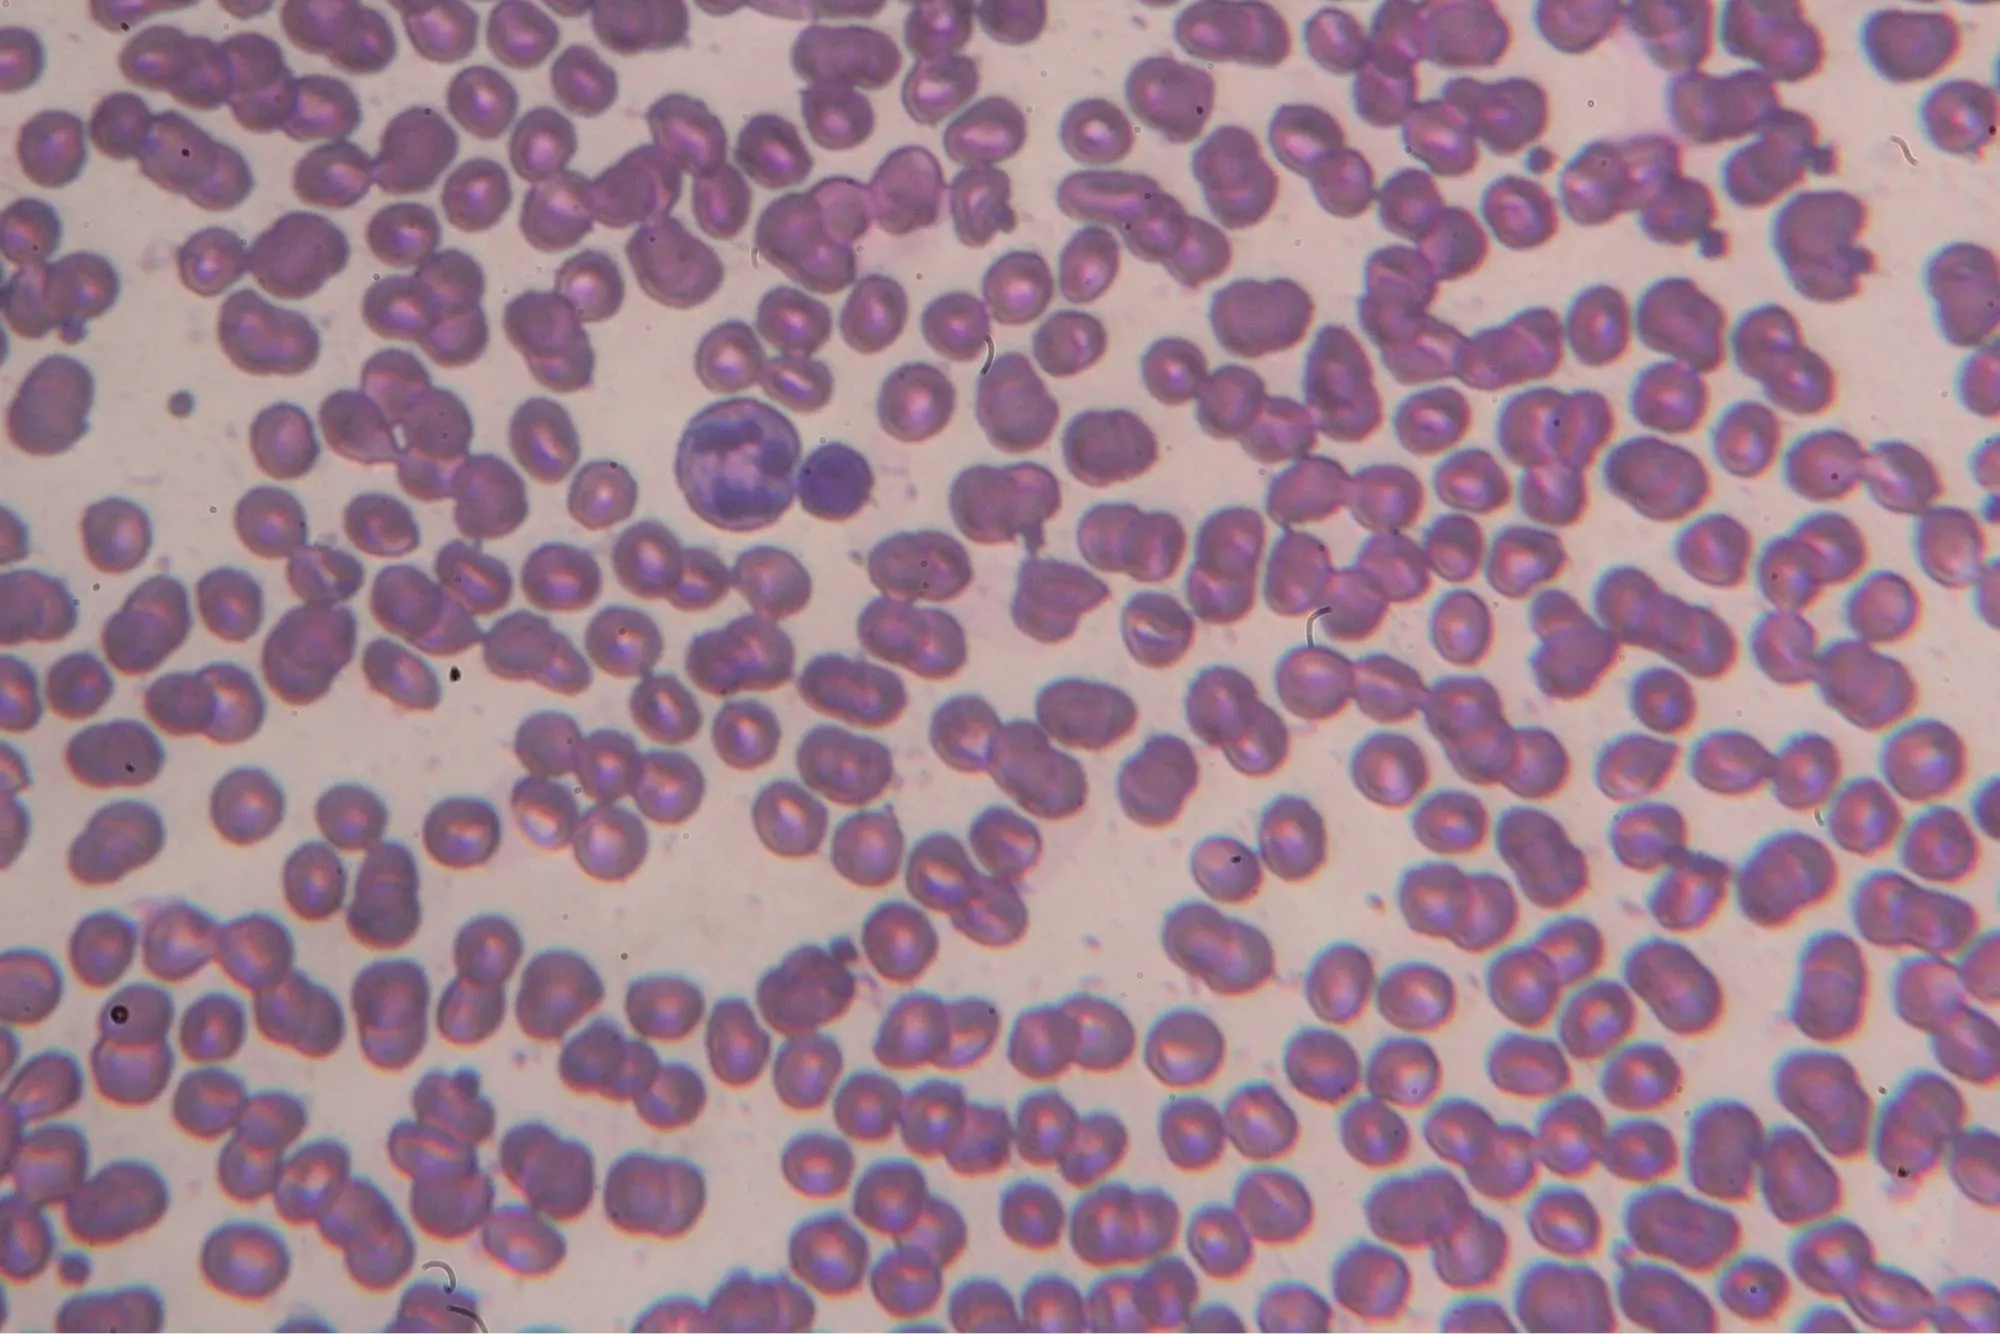
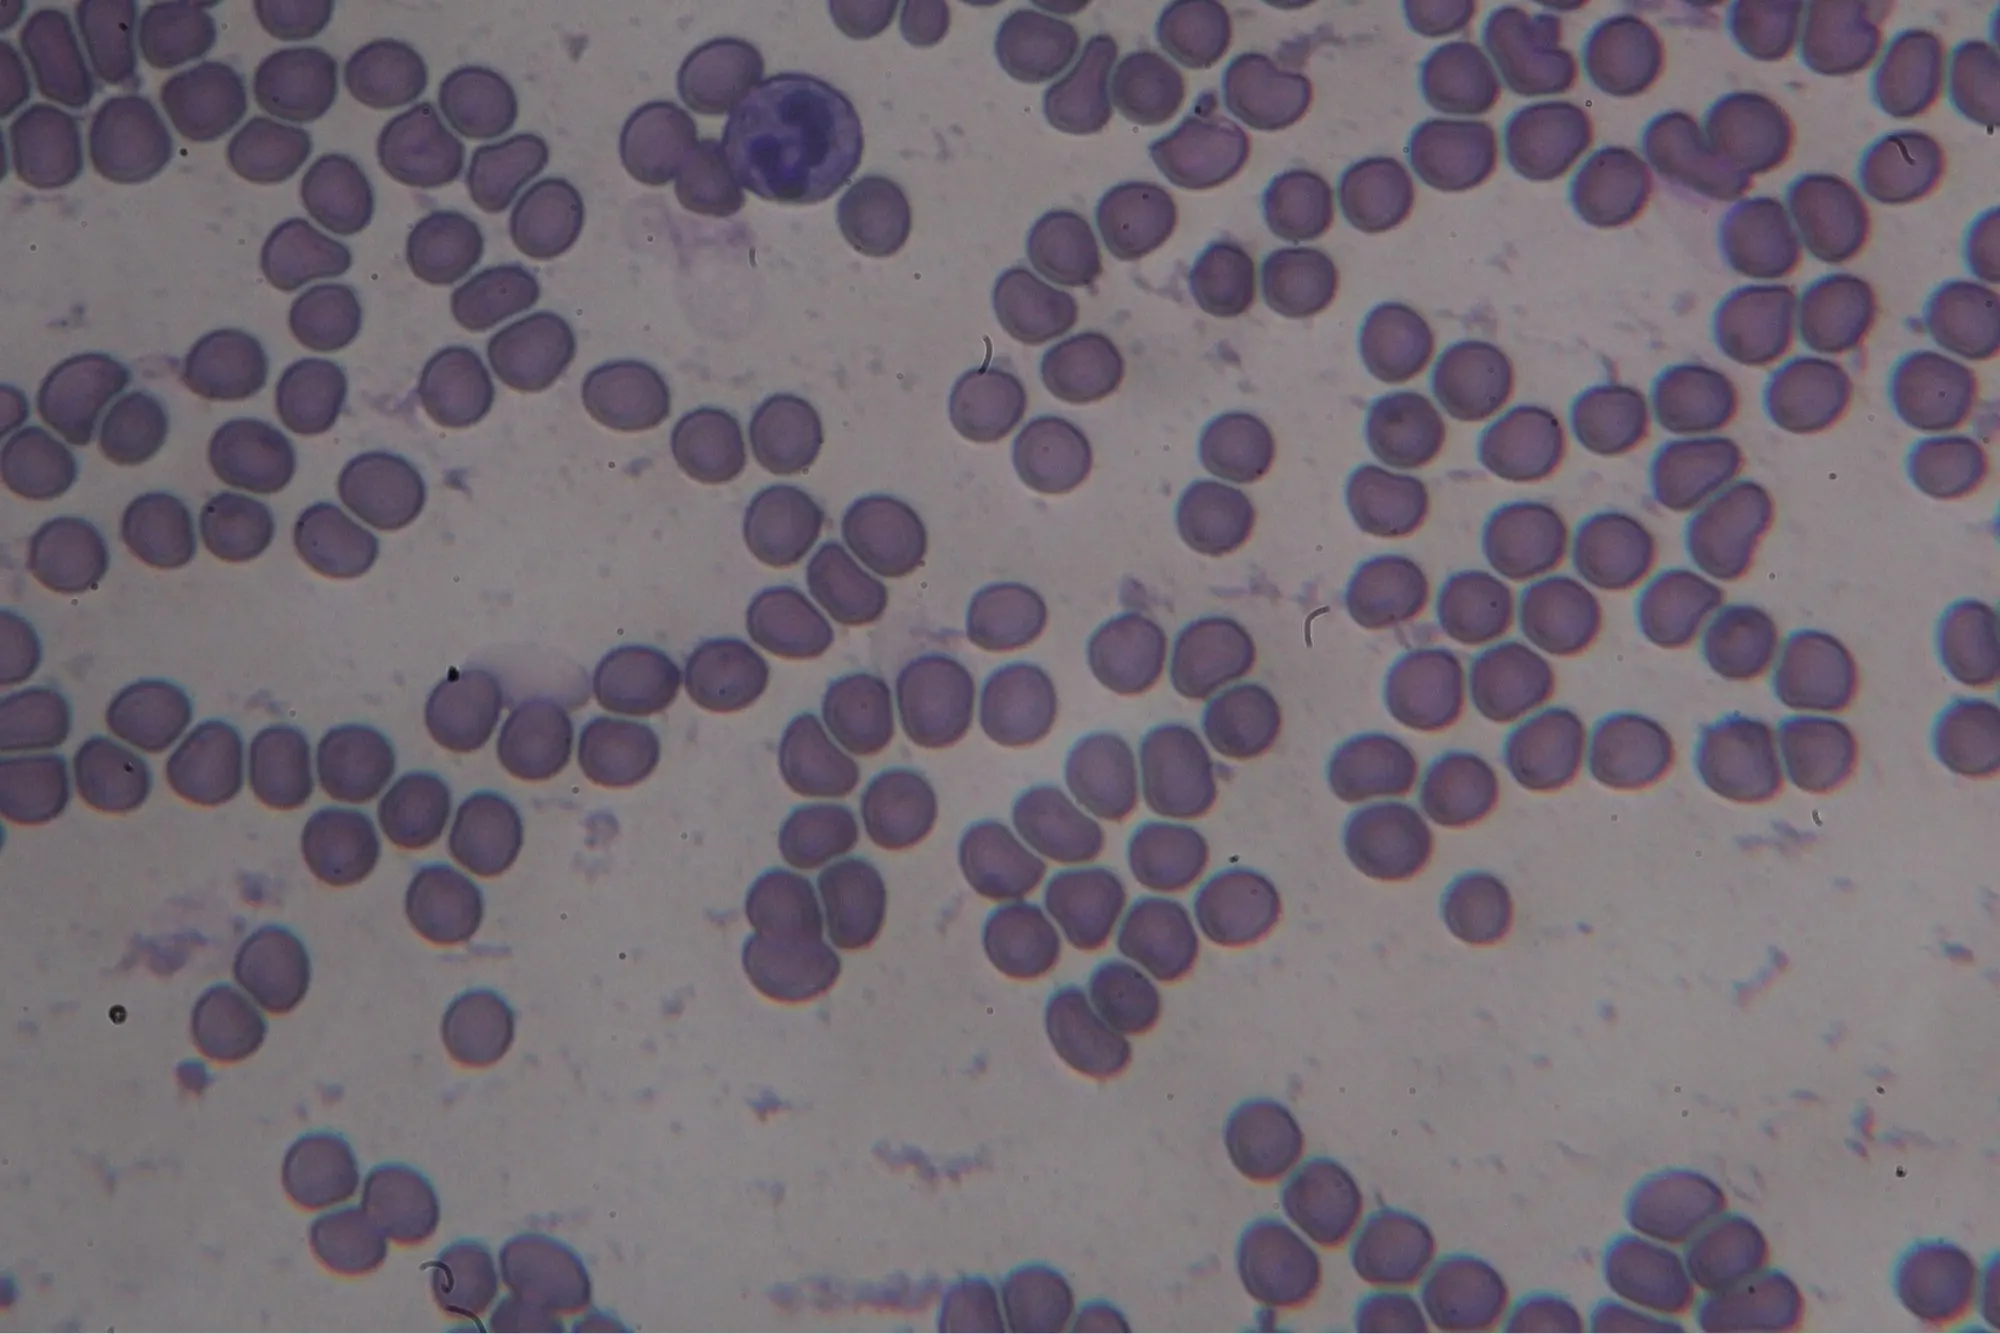

Адаптер объектива металлическое переходное кольцо 23,2 мм Т крепление окуляр микроскопа для Canon EOS крепления SLR камеры Макрос микроскопа Кольцо
7.96
$
18
заказов
/
5
отзывов
История цены
- за 3 месяца
- за полгода
- требуется расширение Alitools
Чтобы следить за товаром и получать уведомления о падении цены, требуется расширение Alitools.
Уведомление о падении цены
7.56 $ (-5%)
7.56 $ (-5%)
7.16 $ (-10%)
6.77 $ (-15%)
6.37 $ (-20%)
Наш Telegram bot уведомит вас как только цена упадет до желаемой
Этот товар у других продавцов
Похожие товары
Отзывы покупателей
F***y
21 августа 2020
На данный момент использовать ещё не успел, но предварительный осмотр оставляет приятное впечатление. Лишних люфтов нет, подогнано всё точно. Из недостатков - если бы внутрення поверхность была покрашена матовой краской, было бы более правильно. Посмотрим, как покажет в деле. Доставка супер быстрая.